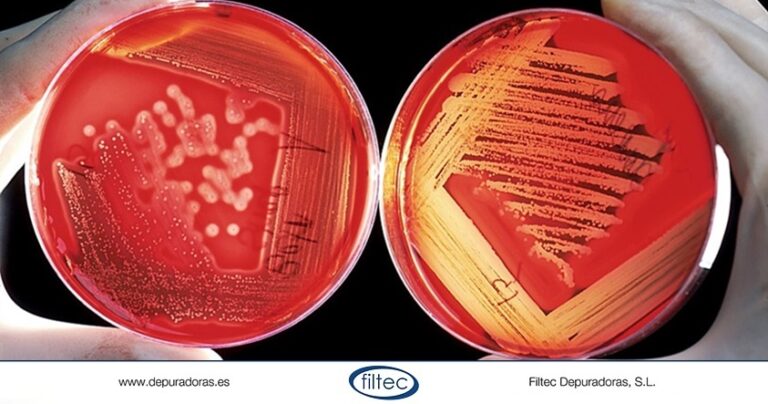

Las bacterias juegan un papel fundamental en la limpieza del agua a través de un proceso natural conocido como biodegradación. Este proceso implica la descomposición de sustancias orgánicas y químicas presentes en el agua por parte de organismos vivos, como las bacterias, que se alimentan de estos contaminantes.
Las bacterias utilizan diferentes mecanismos para descomponer los contaminantes del agua, como la oxidación, la fermentación y la degradación enzimática. Estos procesos permiten que las bacterias transformen los contaminantes en compuestos más simples y menos dañinos para el medio ambiente.
En muchos sistemas de tratamiento de aguas residuales, se utilizan bacterias beneficiosas para eliminar los contaminantes presentes en el agua. Estas bacterias se alimentan de los residuos orgánicos y químicos, ayudando a purificar el agua antes de ser devuelta al medio ambiente. Es importante destacar la importancia de mantener un equilibrio adecuado de bacterias beneficiosas para garantizar la eficacia del proceso de limpieza del agua.
Comprendiendo el papel fundamental de las bacterias en el ciclo del agua
Las bacterias desempeñan un papel crucial en la purificación del agua, ya que son capaces de degradar materia orgánica, consumir nutrientes y eliminar contaminantes presentes en cuerpos de agua. Este proceso es fundamental para mantener la calidad del agua que consumimos y preservar el equilibrio de los ecosistemas acuáticos.
¿Cómo logran las bacterias llevar a cabo esta importante labor de limpieza del agua? La respuesta radica en sus habilidades metabólicas únicas que les permiten utilizar una amplia variedad de compuestos como fuente de energía y alimento. Por ejemplo, algunas bacterias son capaces de descomponer compuestos orgánicos complejos, como el petróleo, mientras que otras pueden convertir amoníaco en nitratos, contribuyendo al ciclo del nitrógeno en el agua.
Un ejemplo destacado de la capacidad de las bacterias para purificar el agua lo encontramos en los sistemas de tratamiento de aguas residuales. En estos sistemas, las bacterias son utilizadas para degradar materia orgánica y nutrientes presentes en las aguas residuales, transformándolos en compuestos menos nocivos y más seguros para el medio ambiente.
Beneficios de la acción bacteriana en la limpieza del agua:
- Reducción de contaminantes: Las bacterias pueden degradar y metabolizar contaminantes químicos y biológicos presentes en el agua, contribuyendo a su purificación.
- Equilibrio ecológico: Al eliminar sustancias nocivas, las bacterias ayudan a mantener el equilibrio de los ecosistemas acuáticos y a preservar la biodiversidad.
- Mejora de la calidad del agua: El papel de las bacterias en la degradación de materia orgánica y nutrientes contribuye a mejorar la calidad del agua que consumimos y utilizamos en diversas actividades.
las bacterias son verdaderas aliadas en la limpieza y purificación del agua, desempeñando un papel esencial en la preservación de los recursos hídricos y en la protección de la salud humana y del medio ambiente.
Métodos biológicos de tratamiento de agua: El papel de las bacterias
El tratamiento biológico del agua es una estrategia cada vez más utilizada para purificar aguas residuales y contaminadas, y las bacterias juegan un papel crucial en este proceso. Estos microorganismos son capaces de degradar contaminantes orgánicos e inorgánicos, convirtiéndolos en compuestos más simples y menos nocivos, lo que resulta en un agua más limpia y segura para el consumo humano y el medio ambiente.
Las bacterias son seleccionadas cuidadosamente y cultivadas en reactores específicos, donde se aprovechan sus capacidades metabólicas para llevar a cabo la depuración del agua. Algunas de las bacterias más comunes utilizadas en los procesos de tratamiento biológico son las bacterias nitrificantes y desnitrificantes, las cuales son capaces de transformar el amoníaco en nitratos y luego en nitrógeno gaseoso, eliminando así este contaminante del agua.
Beneficios de utilizar bacterias en el tratamiento de agua
- Eficiencia: Las bacterias tienen una alta capacidad de degradación de contaminantes, lo que permite un tratamiento efectivo del agua en comparación con métodos químicos.
- Sostenibilidad: El uso de bacterias es una opción más respetuosa con el medio ambiente, ya que no requiere el uso de productos químicos agresivos que pueden generar subproductos tóxicos.
- Economía: A largo plazo, el tratamiento biológico con bacterias puede resultar más económico que otros métodos, ya que el mantenimiento de los reactores biológicos suele ser menos costoso.
Además de su papel en la depuración del agua, las bacterias también son fundamentales en la descomposición de la materia orgánica en los ecosistemas acuáticos, contribuyendo al equilibrio de los nutrientes y al ciclo biogeoquímico del agua.
Las bacterias son aliadas poderosas en la limpieza y descontaminación del agua, ofreciendo una alternativa efectiva, sostenible y económicamente viable para garantizar la calidad del recurso hídrico tan vital para la vida en el planeta.
Estudio de caso: Proyectos exitosos de limpieza de agua con bacterias
En el fascinante mundo de la limpieza del agua mediante bacterias, los proyectos exitosos son un claro ejemplo de cómo la naturaleza puede ser aliada en la resolución de problemas ambientales. A través de diversas investigaciones y pruebas de campo, se ha demostrado la eficacia de utilizar ciertas cepas bacterianas para purificar y descontaminar aguas residuales.
Beneficios de los proyectos de limpieza de agua con bacterias
Los proyectos de limpieza de agua con bacterias ofrecen una serie de beneficios tanto ambientales como económicos. Algunos de los más destacados son:
- Reducción de contaminantes: Las bacterias son capaces de degradar compuestos orgánicos e inorgánicos presentes en el agua, lo que conduce a una disminución significativa de la contaminación.
- Costos operativos bajos: En comparación con otros métodos de tratamiento de aguas residuales, la utilización de bacterias para la limpieza del agua puede resultar más económica a largo plazo.
- Impacto ambiental positivo: Al promover procesos naturales de depuración, se evita el uso de productos químicos nocivos para el medio ambiente.
- Mejora en la calidad del agua: Los resultados de estos proyectos suelen traducirse en una mejora notable en la calidad del agua tratada, lo que beneficia tanto a la flora y fauna acuática como a las comunidades humanas que dependen de ella.
Casos de estudio destacados
A continuación, se presentan dos ejemplos de proyectos exitosos de limpieza de agua con bacterias que han tenido un impacto significativo en la salud de los ecosistemas acuáticos:
| Proyecto | Ubicación | Resultados |
|---|---|---|
| Proyecto A | Costa Rica | Reducción del 80% de la materia orgánica en el agua tratada. |
| Proyecto B | Canadá | Eliminación del 90% de los contaminantes químicos presentes en el agua residual. |
Estos casos demuestran el potencial de las bacterias para limpiar el agua de manera efectiva y sostenible, abriendo la puerta a nuevas estrategias de tratamiento de aguas residuales en todo el mundo.
Perspectivas futuras: Innovaciones y desafíos en la limpieza bacteriana del agua
En un futuro cercano, las bacterias seguirán desempeñando un papel crucial en la limpieza del agua, y se espera que las innovaciones en este campo abran nuevas posibilidades para mejorar la calidad del agua a nivel mundial.
Las tecnologías emergentes basadas en el uso de bacterias ofrecen ventajas significativas en comparación con los métodos tradicionales de tratamiento del agua. Por ejemplo, los sistemas de biofiltración son cada vez más populares debido a su eficacia para eliminar contaminantes orgánicos e inorgánicos del agua de forma sostenible y respetuosa con el medio ambiente.
Beneficios de las tecnologías de limpieza bacteriana del agua:
- Mayor eficiencia: Las bacterias tienen la capacidad de degradar una amplia variedad de contaminantes de forma más eficiente que los métodos químicos convencionales.
- Sostenibilidad: Al aprovechar los procesos biológicos naturales, se reducen los costos energéticos y se minimiza la generación de subproductos nocivos.
- Versatilidad: Las bacterias pueden adaptarse a diferentes condiciones ambientales y tipos de contaminantes, lo que las hace ideales para su implementación en diversas situaciones.
Uno de los principales desafíos que enfrentan los investigadores en este campo es la identificación y selección de las cepas bacterianas más eficaces para la degradación de contaminantes específicos. Mediante estudios genéticos y de biotecnología, se busca potenciar las capacidades de ciertas bacterias para mejorar su rendimiento en la limpieza del agua.
En un mundo donde la escasez de agua limpia es una realidad creciente, la investigación y el desarrollo de tecnologías basadas en bacterias son fundamentales para garantizar un suministro de agua seguro y sostenible para las generaciones futuras.
Preguntas frecuentes
¿Cómo las bacterias pueden limpiar el agua?
Las bacterias utilizan procesos biológicos para descomponer contaminantes en el agua, convirtiéndolos en compuestos menos dañinos.
¿Qué tipo de contaminantes pueden ser eliminados por las bacterias?
Las bacterias pueden eliminar contaminantes orgánicos como aceites, grasas, pesticidas, e incluso compuestos químicos como el nitrato y el amoníaco.
¿Cómo se utilizan las bacterias para purificar el agua a gran escala?
En las plantas de tratamiento de aguas residuales, se utilizan reactores biológicos que aprovechan la acción de las bacterias para eliminar contaminantes de manera eficiente.
- Las bacterias son fundamentales en los procesos de tratamiento de aguas residuales.
- Existen diferentes tipos de bacterias que pueden degradar distintos tipos de contaminantes.
- El proceso de purificación del agua con bacterias se conoce como biodegradación.
- Las bacterias utilizan enzimas para descomponer los contaminantes en formas menos nocivas.
- La presencia de oxígeno es crucial para el crecimiento y actividad de las bacterias en el tratamiento del agua.
- El monitoreo constante de las condiciones del agua y de las bacterias es esencial para garantizar la eficacia del proceso de limpieza.
¡Déjanos tus comentarios y no olvides revisar otros artículos de nuestra web sobre el tratamiento de aguas y la importancia de las bacterias en el medio ambiente!